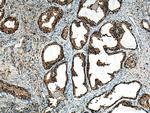
CAPG Antibody in Immunohistochemistry (Paraffin) (IHC (P))

Search
Proteintech
CAPG Polyclonal Antibody
{{$productOrderCtrl.translations['antibody.pdp.commerceCard.promotion.promotions']}}
{{$productOrderCtrl.translations['antibody.pdp.commerceCard.promotion.viewpromo']}}
{{$productOrderCtrl.translations['antibody.pdp.commerceCard.promotion.promocode']}}: {{promo.promoCode}} {{promo.promoTitle}} {{promo.promoDescription}}. {{$productOrderCtrl.translations['antibody.pdp.commerceCard.promotion.learnmore']}}
产品信息
10194-1-AP
种属反应
已发表种属
宿主/亚型
分类
类型
抗原
偶联物
形式
浓度
规格
纯化类型
保存液
内含物
保存条件
运输条件
产品详细信息
Immunogen sequence: HLWIGQQSS RDEQGACAVL AVHLNTLLGE RPVQHREVQG NESDLFMSYF PRGLKYQEGG VESAFHKTST GAPAAIKKLY QVKGKKNIRA TERALNWDSF NTGDCFILDL GQNIFAWCGG KSNILERNKA RDLALAIRDS ERQGKAQVEI VTDGEEPAEM IQVLGPKPAL KEGNPEEDLT ADKANAQAAA LYKVSDATGQ MNLTKVADSS PFALELLISD DCFVLDNGLC GKIYIWKGRK ANEKERQAAL QVAEGFISRM QYAPNTQVEI LPQGRESPIF KQFFKDWK (62-349 aa encoded by BC000728 )
靶标信息
This gene encodes a member of the gelsolin/villin family of actin-regulatory proteins. The encoded protein reversibly blocks the barbed ends of F-actin filaments in a Ca2+ and phosphoinositide-regulated manner, but does not sever preformed actin filaments. By capping the barbed ends of actin filaments, the encoded protein contributes to the control of actin-based motility in non-muscle cells. Alternatively spliced transcript variants have been observed, but have not been fully described.
仅用于科研。不用于诊断过程。未经明确授权不得转售。
生物信息学
蛋白别名: Actin regulatory protein CAP-G; actin-capping protein GCAP39; actin-regulatory protein CAP-G; capping protein (actin filament), gelsolin-like; epididymis secretory protein Li 66; gelsolin-like capping protein; Macrophage-capping protein; myc basic motif homolog 1; unnamed protein product
基因别名: AFCP; CAPG; gCap39; HEL-S-66; mbh1; MCP
UniProt ID: (Human) P40121, (Rat) Q6AYC4
Entrez Gene ID: (Human) 822, (Rat) 297339, (Mouse) 12332